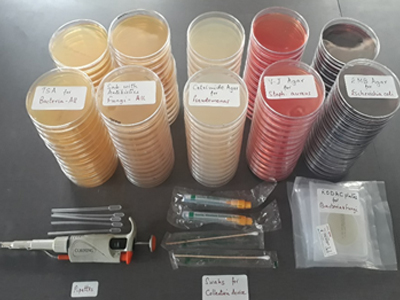
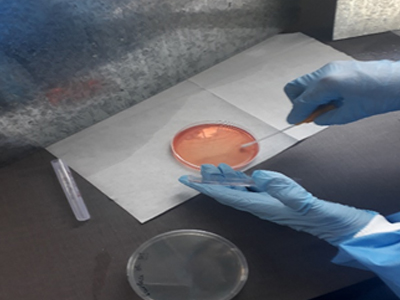
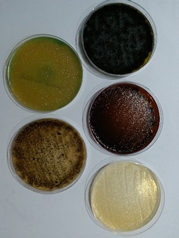
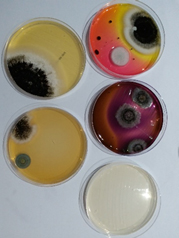
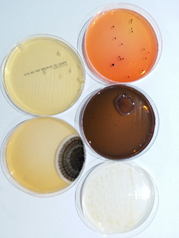
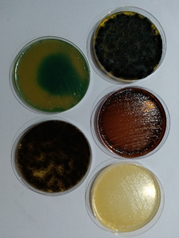
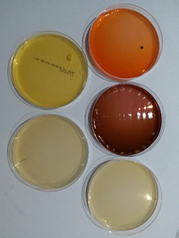
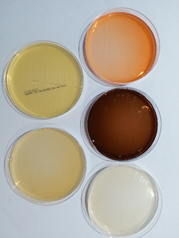
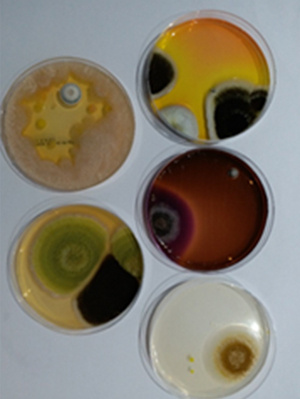
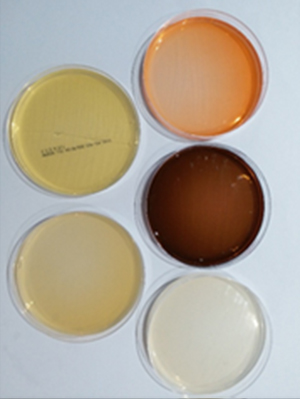
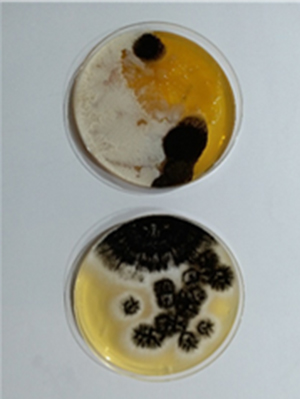
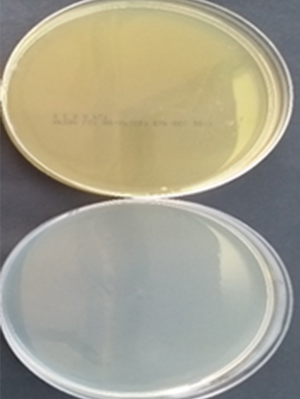

Efficacy of System
System Efficacy - Microbial De-Contamination



- NABL Certified Agency appointed to test and validate the efficacy of the system.
- Testing facility - 2000 Square Ft. Sterilized room with ducted supply and return air.
- Temperature was maintained @ 23 deg C and 50% Rh to simulate a commercial building environment.
- 2 Test plates, one coated with Nano TiO₂ and another without were infected with a consortium of Micro-Organisms and place inside the AHU.

| Sr. | Micro-Organisms | Category | Culture Media |
|---|---|---|---|
| 1 | Staphylococcus aureus | Gram Positive Bacteria | Vojel Johnson (V J) agar |
| 2 | Escherichia coli | Gram Negative Bacteria | Eosin Methylene Blue (EMB) agar |
| 3 | Pseudomonas aeruginosa | Gram Negative Bacteria | Cetrimide agar |
| 4 | Candida albicans | Yeast | Sabourauds Dextrose agar with Antibiotic |
| 5 | Aspergillus niger | Mold |
Methodology - Microbial De-Contamination
- Swab samples from treated and untreated plates are collected and spread over different Culture media (agar plates) to capture specific micro-organism count.
- To monitor the reduction in CFU in air, samples are collected with an Anderson sampler and Gravimetric method.
- The samples are collected at interval of 0 hour to get initial count and further samples are collected after 15 minutes and 180 minutes.

Lab Testing - Microbial Surface and Air Sampling
Sampling Type |
Surface Sampling | Air Sampling | |||||||
|---|---|---|---|---|---|---|---|---|---|
| Test Plate Exposure Time | Gravimetric (Manual) | Anderson Machine | |||||||
| Micro-organism | 0 Mins | 15 Mins | 180 Mins | 15 Mins | 180 Mins | 15 Mins | 180 Mins | ||
| Microbial Count in CFU | Only UVGI | UVGI + PCO | Only UVGI | UVGI + PCO | At Supply Grill | At Centre of Room | |||
| Staphylococcus aureus | >100000 | 21 | 0 | 0 | 0 | 0 | 0 | NA | |
| E. coli | >100000 | 9 | 0 | 0 | 0 | 12 | 0 | ||
| Pseudomonas aeruginosa | >100000 | 180 | 0 | 0 | 0 | 8 | 0 | ||
| Candida Albicans | >100000 | 20 | 0 | 12 | 0 | 22 | 0 | 34 | 0 |
| Aspergillus Niger | >100000 | 8 | 0 | 3 | 0 | 3 | 0 | 14 | 0 |
Microbial Analysis – Surface Sampling
Only UVGI
0 min
100,000 TCFU
100,000 TCFU
15 min
231 TCFU
231 TCFU
180 min
15 TCFU
15 TCFU
UVGI + PCO
0 min
100,000 TCFU
100,000 TCFU
15 min
231 CFU
231 CFU
180 min
15 CFU
15 CFU
Microbial Analysis – Air Sampling
By Gravity Method (Manual)
15 min
45 TCFU
45 TCFU
180 min
0 TCFU
0 TCFU
By Anderson Air Sampler
15 min
45 TCFU
45 TCFU
180 min
0 CFU
0 CFU
| IGBC parameter for Indoor Emission & Microbial Count | Threshold value Class A | Threshold value Class B |
|---|---|---|
| Total Microbial Count | 50 CFU/m³ | 150 CFU/m³ |
Methodology - Efficacy of PCO for VOC & Formaldehyde Reduction
- A mixture of Paint thinner, Cleaning Chemicals, Sanitary Deodorizer & Aerosols (Room freshener) were introduced into the air conditioned space, simulating TVOC counts above Toxic Limits.
- The Graywolf Sensors were setup for monitoring.
- Upon stabilization of TVOC reading, the data logger is started to record the TVOC count and monitor TVOC reduction with the IAQURE system in real time.
- Logging was stopped when the VOC & Formaldehyde count reached the permissible count of 500 µgm/m³
- The process was repeated for the same timeframe without the PCO to determine the TVOC reduction and determine the efficacy of the system.


Proof of Concept – Live Testing
| Benchmark with IGBC – Healthy Building Standards for Micro-organism and TVOC control | ||||||||
|---|---|---|---|---|---|---|---|---|
| Customer | Microbial Count (CFU) Sample Surface Area 25 Sq. cm² |
Microbial Count (CFU/m³) Air Sampling |
TVOC (µg/m³) | |||||
| Pre Installation Oct 2017 |
Post Installation Dec 2017 |
Post Installation Mar 2018 |
Post Installation Mar 2018 |
IGBC Class |
Post Installation Dec 2017 |
Post Installation Mar 2018 |
IGBC Class< |
|
| Customer 1 | 1000++ | 0 | 8 | 77 | B | 60 | 122 | A |
| Customer 2 | 1000++ | 1 | 20 | 48 | A | 357 | 157 | A |
| Customer 3 | 1000++ | 56 | 4 | 34 | A | 75 | 125 | A |
| Customer 4 | 1000++ | 55 | 4 | 28 | A | 89 | 147 | A |
| Customer 5 | 1000++ | 2 | 10 | 127 | B | 201 | 140 | A |
| IGBC Threshold values for Microbial Count & VOC & Formaldehyde : 50 CFU/m³ & 500 µg/m³ for “ Class A “ 150 CFU/m³ & 650 µg/m³ for “ Class B” respectively , as per ASHRAE standard . | ||||||||
Iaqure® Advantages
IAQURE® solution is Green Pro certified
IAQURE® Indoor Air Quality Analyzer is Green Pro certified
UL Certified UVGI system
Increased Productivity & Lower Absenteeism
Improved Heat Transfer – Power Savings
Enhanced Coil Life – Lower Maintenance Costs
Enquiry